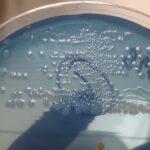
Proteus mirabilis- Introduction, Morphology, Pathogenicity, Lab Diagnosis, Treatment, Prevention, and Keynotes

Tag: Swarming motility
Proteus vulgaris: Introduction, Morphology, Pathogenicity, Lab Diagnosis, Treatment, Prevention, and Keynotes
Introduction Proteus vulgaris is a Gram-negative, rod-shaped bacterium that belongs...
Read MoreProteus mirabilis- Introduction, Morphology, Pathogenicity, Lab Diagnosis, Treatment, Prevention, and Keynotes
Introduction Proteus mirabilis is a Gram-negative bacterium known for its...
Introduction Proteus mirabilis is a Gram-negative bacterium known for its...
